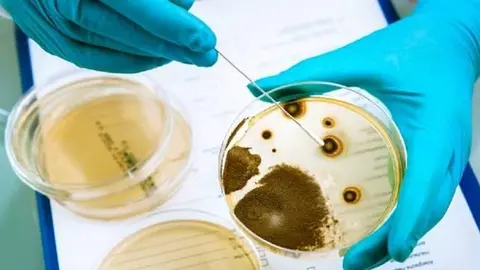
Germs growing on an agar plate in laboratory

600.000 turistas tirados por el mundo por la quiebra de Thomas Cook
23/9/19
Uno de los países más afectados por la quiebra del gigante empresarial turístico es España